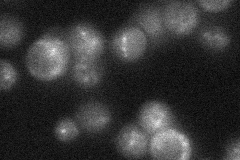
YLR240W
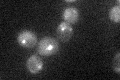
YLR240W
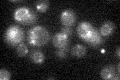
YLR240W

View description
Phosphatidylinositol 3-kinase responsible for the synthesis of phosphatidylinositol 3-phosphate; forms membrane-associated signal transduction complex with Vps15p to regulate protein sorting; activated by the GTP-bound form of Gpa1p
Localization:
Intensity:
Fold change:
Significance:
-
C’ GFP library in SD

punctate21.45 -
N' NOP1pr-GFP in SD

cytosol,punctate48.9015 -
N' TEF2pr-mCherry in SD

cytosol,punctate53.8626 -
N' NATIVEpr-GFP in SD
punctate24.9314 -
N' TEF2pr-VC and Cyto-VN in SD

cytosol30.1334 -
C’ GFP library in SD+DTT

punctate17.90.83No -
C’ GFP library in SD+H2O2
punctate18.170.84No -
C’ GFP library in Starvation Media
punctate21.931.02No -
C’ GFP library on the background of Pup2-DaMP

punctate -
C’ GFP library on the background of CCT mutant

punctate15.76740.734676No
